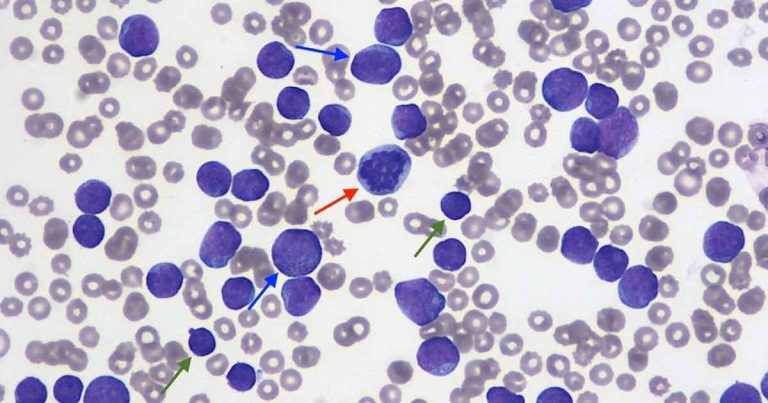
Unexpected findings in a dog with peripheral leukocytosis

17 Jun 2019
Francesco Cian discusses a blood sample from an adult neutered poodle in the latest Haematology Hub.
Figure 1.
The image (Figure 1; Wright-Giemsa 50×) and data (Table 1) are from an ethylenediamine tetra-acetic acid (EDTA) blood sample of an adult male neutered poodle dog with a clinical history of inappetence, anorexia and lethargy.
Evidence exists of a very marked leukocytosis, confirmed on examination of the blood smear. The vast majority of these leukocytes (more than 90%) are atypical, intermediate to large, round cells (blue arrows). They have small amounts of basophilic/blue cytoplasm and an intermediate to large size nucleus, round, occasionally indented, with granular chromatin and poorly visible nucleoli. Mitotic figures (red arrow) are seen. The degree of leukocytosis and the cell morphology observed are supportive of a neoplastic proliferation and, in particular, of acute leukaemia.
A few small lymphocytes (green arrows) are also seen, but no neutrophils. The almost complete lack of neutrophils (neutropenia), together with very low platelet numbers (thrombocytopenia) and moderate, poorly regenerative anaemia, is defined as pancytopenia. This indicates inability of the bone marrow to produce new haematopoietic cells and may be due to several conditions including neoplasia, where tumoural cells may efface most of the normal bone marrow tissue.
Flow cytometry is the most appropriate test and can be performed from fresh EDTA blood in selected diagnostic laboratories. This diagnostic procedure identifies cells based on specific antigens expressed on their surface, which are referred to as clusters of differentiation (CDs). Most acute leukaemias are positive to CD34, which is a glycosylated type 1 transmembrane protein expressed on the cell surface of immature haematopoietic cells.
Depending on this leukaemia being lymphoid or myeloid, cells will express additional selected markers. In this case, more than 90% of neoplastic cells expressed CD3 and CD5 (both T-cell markers), and the patient was diagnosed with T-cell acute lymphoid leukaemia. After one week, the patient continued to deteriorate and so the owners elected for euthanasia.
Acute leukaemias are rapidly progressive and poorly responsive to chemotherapy, and hence, can be an extremely discouraging diagnosis for both clinician and owner.